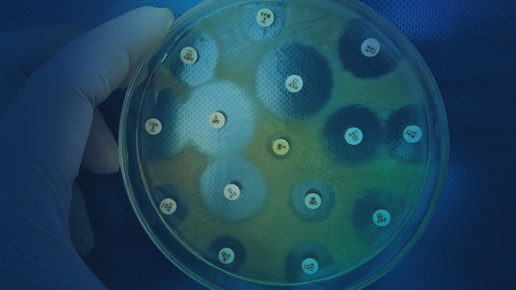

Sonderregel für DocMorris / Phoenix: Kein Wiederaufbau / Widerrufsrecht bei Versendern / Antibiotika
Eigentlich hatte DocMorris schon vor drei Jahren vom Oberlandesgericht Düsseldorf (OLG) einen Freibrief bekommen, was den Nachweis einer öffentlichen Apotheke am Standort in Heerlen angeht. Doch der Bundesgerichtshof (BGH) hat völlig überraschend Zweifel angemeldet und schickt die Sache zur gründlichen Prüfung zurück. / Nach einem Großbrand wird die Phoenix-Niederlassung in Freiburg nicht wieder aufgebaut. Das Megafeuer vernichtete den Betrieb Anfang Oktober. / Versandapotheken müssen damit leben, dass sie Verbraucherinnen und Verbrauchern ein Widerrufsrecht einräumen müssen, auch wenn sie retournierte Arzneimittel nicht wieder in Verkehr bringen dürfen. / Experten warnten auf einer Veranstaltung von Pharma Deutschland anlässlich der Welt-Antibiotika-Woche vor einer drohenden Versorgungslücke.

APOTHEKE ADHOC Debatte